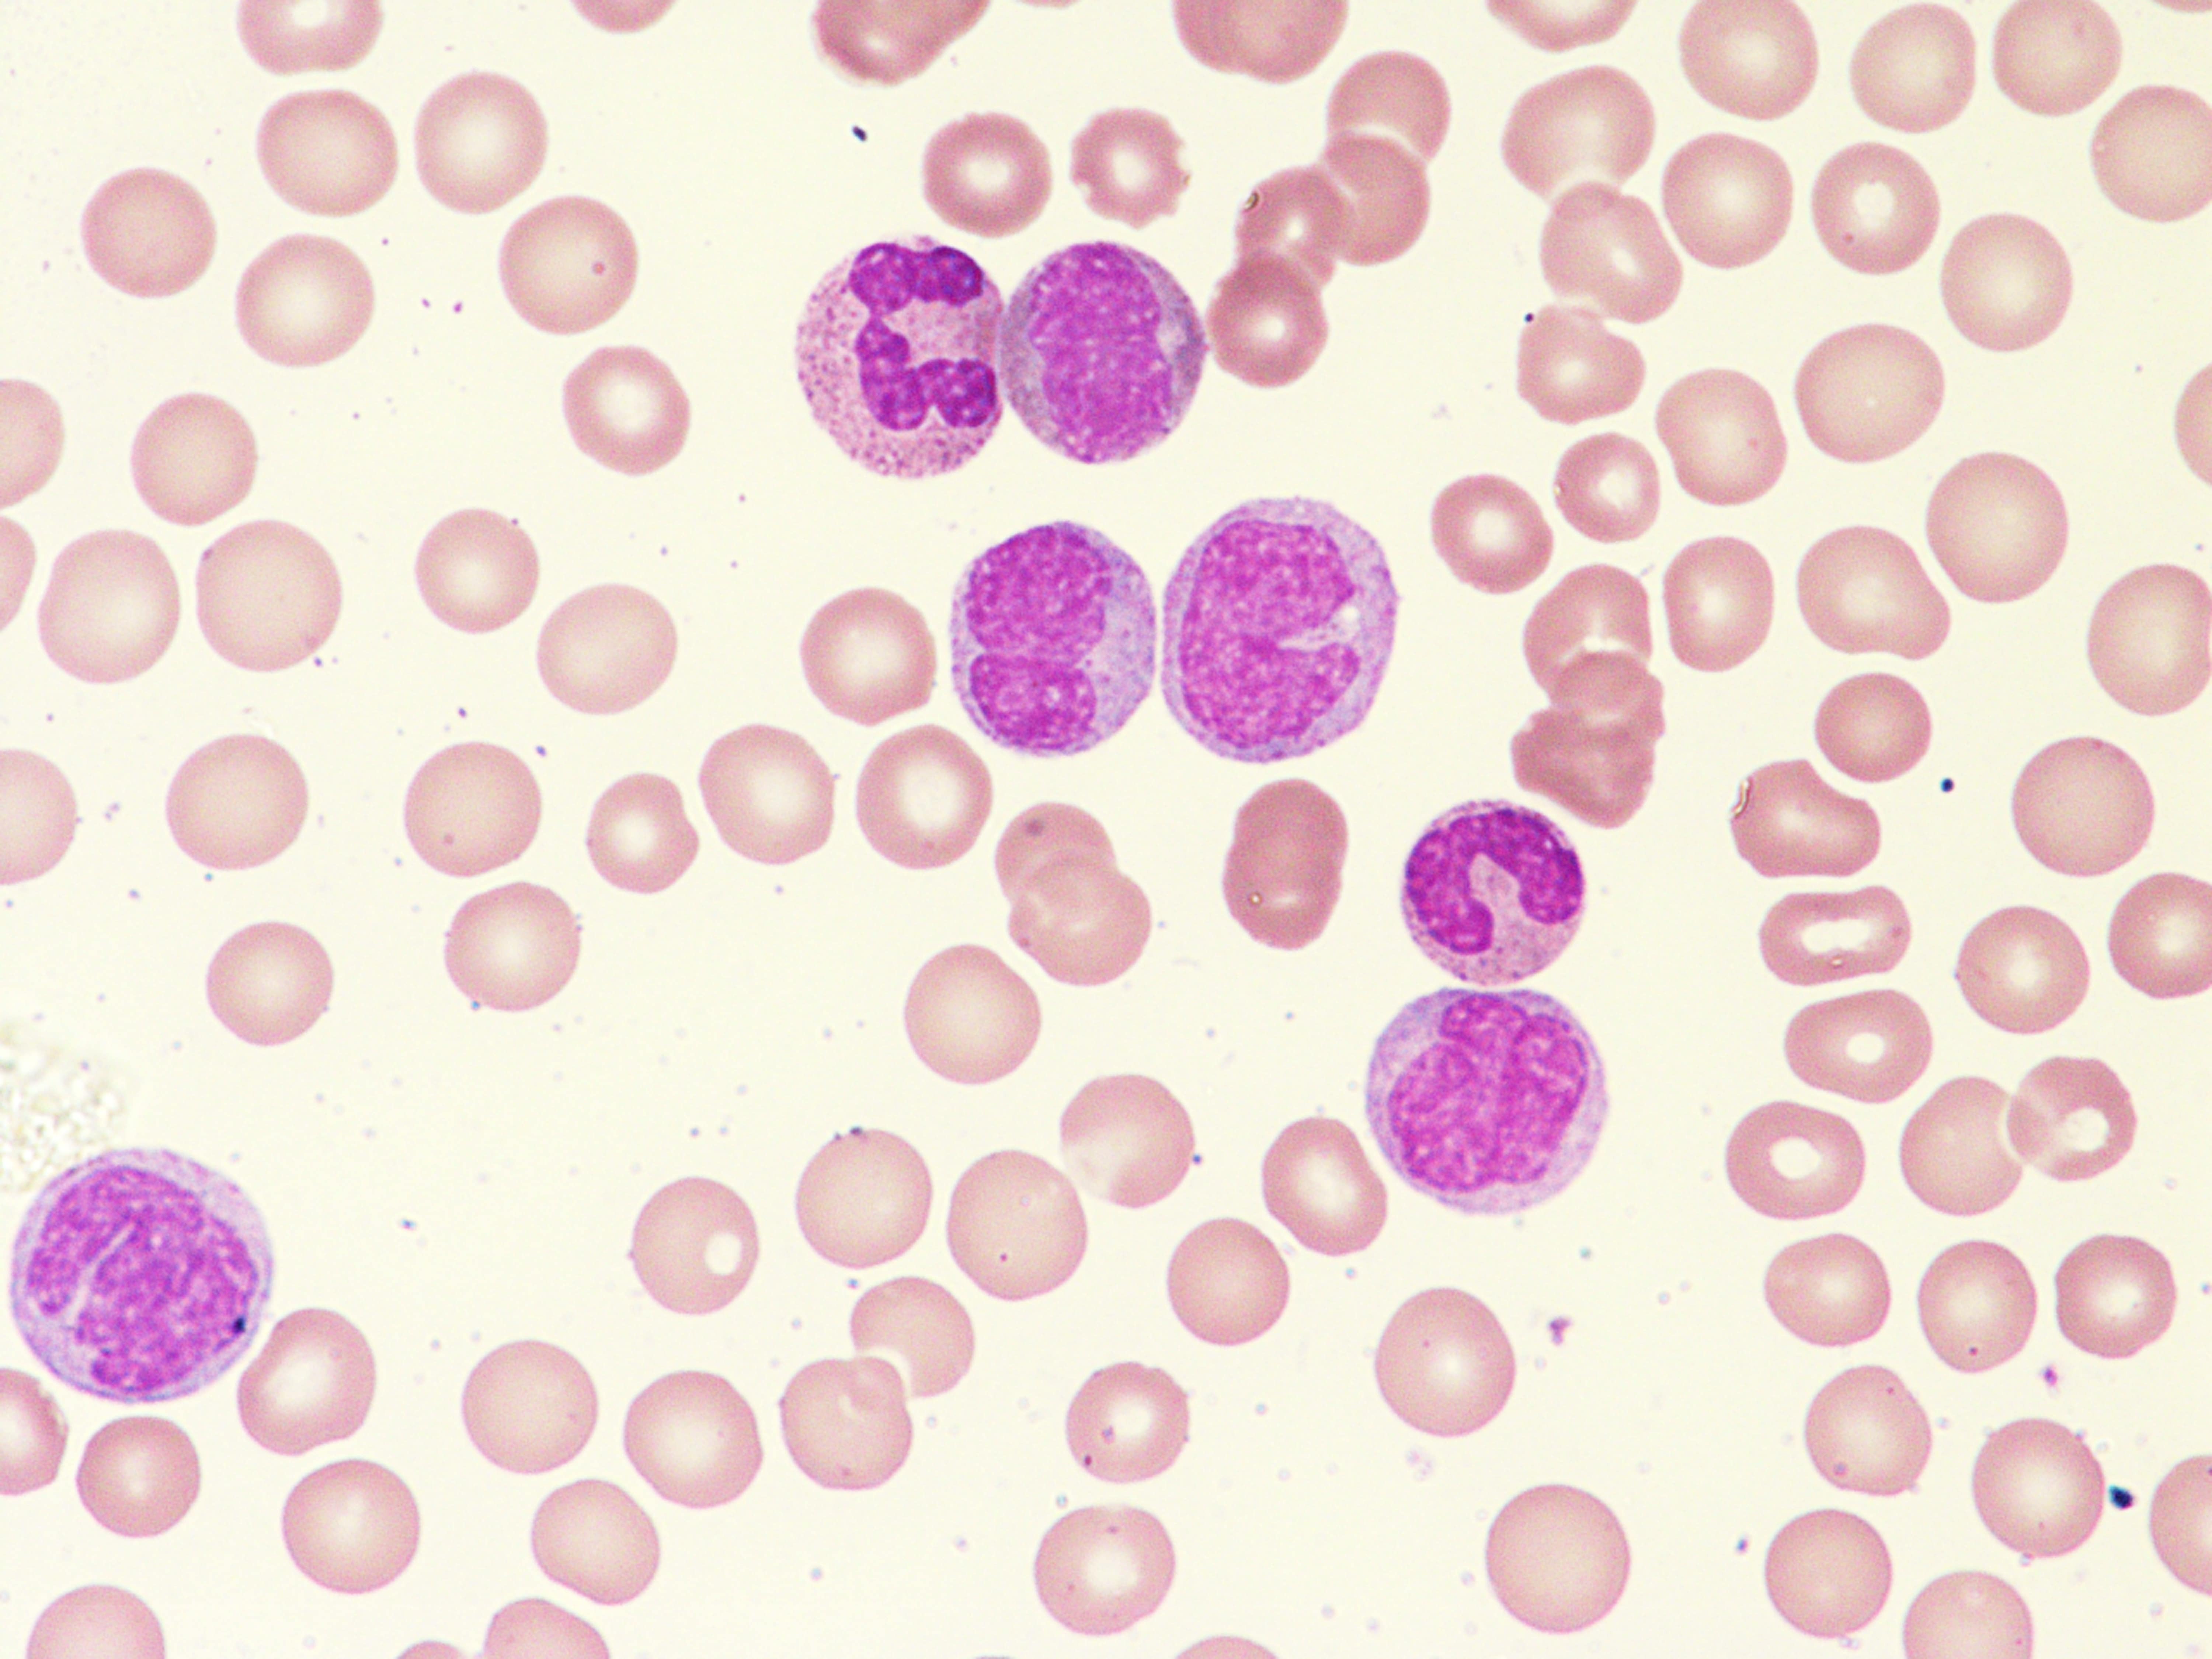

-
- Research
- Research Topics
-
- Research Platforms & Services
- Clinical & Research Imaging Centre (CRIC)
- PIRL (Preclinical, Imaging and Research Laboratories)
- Molecular Imaging and Therapy Research Unit (MITRU)
- Brain Organoid Therapeutics (BOT)
- Clinical Trials Platform
- Health Policy Centre
- SAHMRI Registry Centre
- South Australian Genomics Centre (SAGC)
- Research Integrity
- Community Engagement in Research